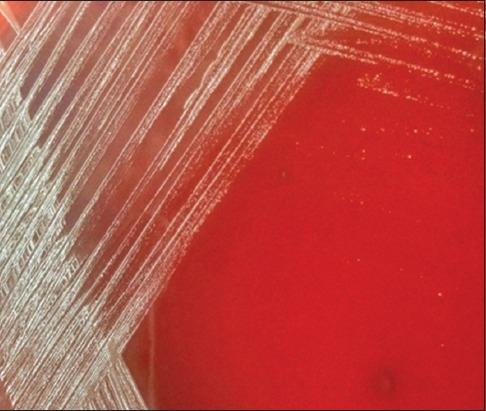

雌性山羊自然发生的生殖疾病的分子病因病理学
Molecular etiopathology of naturally occurring reproductive diseases in female goats.
作者信息
Beena V, Pawaiya R V S, Gururaj K, Singh D D, Mishra A K, Gangwar N K, Gupta V K, Singh R, Sharma A K, Karikalan M, Kumar Ashok
机构信息
Division of Animal Health, ICAR-Central Institute for Research on Goats, Makhdoom, Farah, Mathura - 281 122, Uttar Pradesh, India.
Centre for Animal Disease Research and Diagnosis (CADRAD), ICAR-Indian Veterinary Research Institute, Izatnagar - 243 122, Uttar Pradesh, India.
出版信息
Vet World. 2017 Aug;10(8):964-972. doi: 10.14202/vetworld.2017.964-972. Epub 2017 Aug 22.
AIM
The aim of the present study was to investigate the molecular etiopathology of occurrence of reproductive diseases in female goats. Reproductive diseases in goats account for major economic losses to goat farmers in terms of valuable loss of offspring and animal productivity.
MATERIALS AND METHODS
A total of 660 female genitalia were examined for pathological conditions (macroscopic and microscopic lesions). The etiopathological study was carried out for the presence of pathogenic organisms such as , , and in the uterus and ovary. Based on the microscopic lesions, suspected samples were subjected to diagnostic polymerase chain reaction (PCR) for various etiological agents employing 16srRNA genus specific primers for and and gene-based PCR for and nested PCR using gene primers for . For suspected samples, immunohistochemistry (IHC) was also performed.
RESULTS
In studied female genitalia, 108 (16.30%) showed gross abnormalities with overall 23.32% occurrence of pathological conditions (macroscopic and microscopic lesions). Pathological involvement of the uterus was the highest 68 (62.96%), followed by the ovaries 27 (25%) and other organs. Major uterine condition observed was endometritis (5.60%). In uterine infections, 35 (5.30%) samples were found positive for spp., 12 (1.81%) samples for , and 3 (0.45%) samples were positive for spp. Among the samples positive for by PCR, 3 were found positive by IHC also. was detected by PCR using specific primers in a case of hydrosalpinx. It was concluded that many pathological lesions in female genitalia of functional significance play a major role in infertility in goats.
CONCLUSION
The present study concluded that many pathological lesions in female genitalia of functional significance play a major role in infertility in goats.
目的
本研究旨在探讨雌性山羊生殖疾病发生的分子病因病理学。山羊的生殖疾病在后代的宝贵损失和动物生产力方面给养羊户造成了重大经济损失。
材料与方法
共检查了660个雌性生殖器的病理状况(宏观和微观病变)。对子宫和卵巢中是否存在诸如[具体病原体1]、[具体病原体2]和[具体病原体3]等致病生物进行病因病理学研究。根据微观病变,对疑似样本进行诊断性聚合酶链反应(PCR),针对各种病原体使用16srRNA属特异性引物检测[具体病原体1]和[具体病原体2],使用基于[具体基因名称1]基因的PCR检测[具体病原体3],并使用[具体基因名称2]基因引物进行巢式PCR检测[具体病原体4]。对于[具体数量]个疑似样本,还进行了免疫组织化学(IHC)检测。
结果
在所研究的雌性生殖器中,108个(16.30%)出现肉眼可见异常,病理状况(宏观和微观病变)的总体发生率为23.32%。子宫的病理累及率最高,为68个(62.96%),其次是卵巢,为27个(25%),其他器官。观察到的主要子宫病症是子宫内膜炎(5.60%)。在子宫感染中,35个(5.30%)样本检测出[具体病原体1]属阳性,12个(1.81%)样本检测出[具体病原体2]阳性,3个(0.45%)样本检测出[具体病原体3]属阳性。在PCR检测为[具体病原体1]阳性的样本中,有3个通过IHC检测也呈阳性。在一例输卵管积水病例中,使用特异性引物通过PCR检测到了[具体病原体4]。得出的结论是,雌性生殖器中许多具有功能意义的病理病变在山羊不育中起主要作用。
结论
本研究得出结论,雌性生殖器中许多具有功能意义的病理病变在山羊不育中起主要作用。